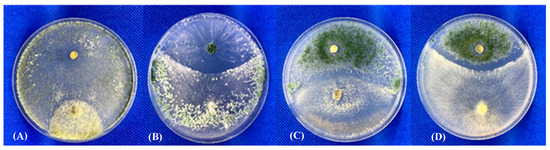

Abstract
Nine isolates of Trichoderma were obtained from the diverse phases of compost preparation and the production of different commercial varieties of oyster mushrooms Pleurotus spp. with the apparent presence of green mould disease. The isolates were morphologically and genetically characterized. Molecular fingerprinting indicated that the isolates belonged to the species T. pleuroticola and T. harzianum. In order to identify control measures, changes in temperature, pH, and application of fungicides were tested on the present isolates, using known Trichoderma biocontrol strains as a reference. Fungicide effects on the growth of Pleurotus isolates were also assessed. The optimal growth temperatures were 25 °C for Trichoderma isolates and 28 °C for Pleurotus isolates, and Trichoderma always grew faster than Pleurotus. In particular, a reduction of about 30% was recorded for some of the Trichoderma isolates when comparing the colony growth at 25 and 28 °C. Trichoderma isolates developed well within a wide pH range, with the best growth occurring between pH 5 and 7, whereas Pleurotus preferred more alkaline conditions (pH 8 to 9). Prochloraz and metrafenone were found to inhibit Trichoderma growth with different dose responses that did not affect the growth of Pleurotus spp. In particular, metrafenone was the most effective active ingredient that inhibited the majority of the Trichoderma isolates (1–25% growth reduction).
1. Introduction
Filamentous fungi belonging to the genus Trichoderma can live as ubiquitous saprophytes in both natural and agricultural ecosystems. They are active secondary opportunists commonly found in the soil, grow rapidly on many diverse substrates, and are prolific producers of spores that are readily transported by wind or dust. In addition, their distribution is associated with the movement of humans, animals, insects, and mites, and they are frequently disseminated by agricultural machinery and products [1,2,3,4]. Some species of this genus have been extensively studied as biological control agents and utilized as the active ingredient in many commercial biopesticides and biostimulants [5,6,7].
In 1985, an epidemic of green mould disease caused by Trichoderma spp. surfaced in the production of Agaricus bisporus in Northern Ireland, subsequently followed by severe infestations in mushroom farms in other locations of the United Kingdom, Spain, Germany, the Netherlands, the United States, and Canada. It has been estimated that the worldwide economic losses incurred by the champignon mushroom industry in the 10 years following the initial outbreak exceeded USD 30 million, with production losses oscillating between 30 and 100% [8,9,10,11,12,13,14,15,16]. In Italy, a problem with Trichoderma infestations appeared in the production of another edible commercial mushroom, Pleurotus ostreatus (oyster mushroom). The disease initially appeared around 2002 in the northern regions and expanded in the following years to the southern (and other) Mediterranean regions. The disease caused dramatic yield losses and a drastic decrease in production within the oyster mushroom industry [17].
The compost used in industrial mushroom production is host to both innocuous as well as aggressive isolates of Trichoderma, which cannot be morphologically distinguished from one another [13,18,19,20]. The richness of the compost/substrate in holocellulose compounds, i.e., hemicellulose, cellulose, and lignin, which are high energy sources for fungal populations, encourages Trichoderma proliferation [21,22]. Among the isolates obtained from the infested A. bisporus compost, four different biological forms of Trichoderma were found. Two were not pathogenic to A. bisporus, namely T. harzianum (formerly classified as T. harzianum biotype Th1), which taxonomically includes the ex-neotype strain of T. harzianum [20] as well as many biological control strains [13,19,23,24], and T. atroviride (formerly classified as T. harzianum biotype Th3). The pathogenic form found in Europe (formerly classified as T. harzianum biotype Th2) [25,26] was identified as T. aggressivum forma europaeum [13]. Further, the Trichoderma species typically found in North America, pathogenic to champignon mushrooms, differed from the European species and was taxonomically designated as T. aggressivum f. aggressivum (formerly designated as T. harzianum biotype Th4 [13,27,28]).
Interestingly, it has been determined that some Trichoderma species associated with Pleurotus production are taxonomically different from those found aggressive to A. bisporus, and these species were identified as T. pleuroticola and T. pleuroti [23,29,30]. The distribution of T. pleuroticola and T. pleuroti species in Pleurotus compost appears variable; for example, the majority of the Hungarian isolates belonged to T. pleuroti, whereas most of the Italian isolates belonged to T. pleuroticola [30].
The problem with Trichoderma spp. infestions in Pleurotus production is relatively new in comparison to the situation with Agaricus [13,17,20,31].
As characteristic of all substrates infected with Trichoderma, the typical symptoms or signs of the disease can be recognised by the formation of green mould (due to the conidia) on the cultivated mushrooms and compost, which, in cases of acute outbreaks, results in a total loss of production due to contamination [32,33].
T. pleuroticola has been found on the natural substratum of the oyster mushroom, both on the commercially cultivated varieties as well as the wild P. ostreatus, whereas T. pleuroti has been found only on the cultivated P. ostreatus and its substrate [34,35].
Woo et al. [17] reported that Trichoderma spp. was only found at the initial phase of substrate preparation and disappeared after pasteurization at 60 °C for 10 h. However, Trichoderma spp. was detected again at the spawn run stage when temperatures reached ca. 30 °C. The optimal mycelial growth of the green mould occurred at 80% relative humidity. A substrate of around pH 8–9 may slow the growth of Trichoderma spp., resulting in a decrease in infection spread [2].
In the present study, we characterized the Trichoderma spp. associated with Pleurotus ostreatus and P. eryngii displaying signs of green mould disease in order to (1) monitor fungal presence during the processing phases; (2) isolate and identify the associated Trichoderma; (3) test potential control methods, in particular by manipulation of physical factors affecting Trichoderma spp. growth and development; and (4) test two approved fungicides to determine the effective doses for controlling Trichoderma, without producing undesirable consequences for Pleurotus spp.
2. Materials and Methods
2.1. Fungal Isolation from Oyster Mushroom Production Chain
Trichoderma spp. were isolated from green mould-infected samples collected during different phases of compost preparation used for growing Pleurotus ostreatus and P. eryngii at the company Saipan S.r.l. (Cava de Tirreni, Salerno, Italy) and at nearby mushroom houses during the first fruiting stage of oyster mushrooms in 2007. During this period, Saipan produced about 1 million substrate bales (approx. 17 kg each), pre-inoculated with different isolates of Pleurotus, which were transferred after about 20 days of incubation to mushroom farms throughout the country.
The samples were collected at different stages of mushroom production. Ten grams of compost material were suspended in 100 mL of distilled water and agitated for one hour at room temperature, and aliquots from a logarithmic dilution series were spread onto potato dextrose agar (PDA; Himedia laboratory, Mumbai, India). Standard microbiological protocols were used for determining the number of colony-forming units (CFUs) over a 5 day period, and for isolating, purifying, and storing the Trichoderma isolates. Three biological control agents of Trichoderma: T. atroviride strain P1 (ATCC74058), T. atroviride strain A6, and T. afroharzianum strain T22 (ATCC20847) were included in the experiments for comparison to the putative pathogenic isolates.
Different commercial oyster mushroom spawns (or seeds) were obtained from the compost producer comprising eleven strains of P. ostreatus (coded as HK45, M6, P6, P15, P24, P77, P107, P145, PC3, PF4, and PLC), and one isolate each of P. eryngii (P47, “cardoncello” mushroom), and Pholiota aegerita (AFO, “pioppino” mushroom). Regardless of the genus or species, all the oyster mushroom isolates will be referred to hereafter as “Pleurotus”. The grains of “seed” inoculum were placed on PDA plates to obtain mycelium cultures that were conserved as PDA slants under mineral oil.
2.2. Effect of Temperature on Fungal Growth
Young starter fungal cultures of Trichoderma and Pleurotus were maintained on PDA at 25 °C. A 5 mm disk of each culture was transferred to the centre of a new Petri plate (90 mm diameter) containing PDA and incubated in the dark at temperatures of 25, 28, and 35 °C to determine the effect of temperature on mycelium development [13,36]. The colony diameter was measured at 24 h intervals. In addition, the time of the appearance of green spores, the characteristics of the colony growth, and the pigmentation of the mycelium were recorded. The experiment consisted of three replicates for each fungal isolate and was repeated on three separate occasions.
2.3. Effect of pH on Fungal Growth
A 5 mm disk of young PDA cultures of Trichoderma and Pleurotus was transferred to 24-well plates containing 1 mL of Potato Dextrose Broth (PDB, Himedia laboratory, Mumbai, India) adjusted to pH values of 4, 5, 6, 7, 8, or 9 with HCl or KOH (control = PDA at pH 5.5) and incubated at 25 °C in the dark. The colony growth was evaluated at 24 hour intervals by using an established evaluation scale based on five values: 0 = no apparent fungal growth (dead or severely inhibited, dimension of the initial inoculum unchanged), 1 = minimal fungal growth (1 to 25% of the growth of the control, growth barely exceeds the initial inoculum), 2 = medium fungal growth (26 to 50% of the control), 3 = good fungal growth (51 to 75% of the control), and 4 = very good fungal growth (no apparent inhibition, 76 to 100% of the control).
2.4. Genetic Characterization
Genomic DNA was extracted from all Trichoderma isolates following the modified protocol of Manganiello et al. [37]. The isolates were grown in PDB on a rotary shaker at 150 rpm for 96 h at 25 °C. Fresh mycelium was collected after vacuum filtration through No. 4 Whatman filter paper (Whatman Biosystems Ltd., Maidstone, UK), frozen in liquid nitrogen, ground to a fine powder, and immediately processed.
Total genomic DNA was extracted from 100 mg of ground mycelium using the Macherey-Nagel™ NucleoSpin™ Soil (MN) (Düren, Germany) according to the manufacturer’s protocol. The internal transcribed spacer and translation elongation factor 1α (TEF1) amplifications were performed using Phusion polymerase in a MiniAmp Thermal Cycler (Thermo Fisher Scientific, Waltham, MA, USA). Primers ITS-1 (5′-CTTGGTCATTTAGAGGAAGTAA-3′) and ITS-4 (5′-TCCTCCGCTTATTGATATGC-3′) were used to amplify a fragment (~0.6 kb) of rDNA, including ITS-1 and ITS-2 and the 5.8S rDNA gene (White et al., 1990), whereas the 5′ portions of translation elongation factor 1α (~0.8 kb) were amplified with primers TEF1-F (5′-ATGGGTAAGGARGACAAGAC-3′) and TEF1-R (5′-GGARGTACCAGTSATCATGTT-3′) (O’Donnell et al., 1998) by using the following parameters: denaturation at 98 °C for 30 s; 35 cycles of denaturation at 98 °C for 10 s; annealing at 55 °C for 30 s; extension at 72 °C for 40 s; final extension at 72 °C for 5 min.
Amplicons were separated by gel electrophoresis on 1% w/v agarose supplemented with SYBR Safe DNA Gel Stain (Invitrogen, Paisley, UK). Amplicon sizes were determined by comparison to a 1 Kb bp DNA ladder marker (InvitrogenTM, ThermoFisher Scientific, Waltham, MA, USA). PCR products were purified using the PureLinkTM PCR Purification Kit (InvitrogenTM, ThermoFisher Scientific, Waltham, MA, USA) following the manufacturer’s instructions. The concentrations of DNA were determined using a QubitTM fluorometer with a dsDNA BR Assay KitTM (Thermo Fisher Scientific, Wilmington, DE, USA). Samples were sent for sequencing to Eurofins Genomics, and then DNA sequences were blasted against the NCBI GenBank and Trichoblast databases; all sequences obtained in this study were deposited to NCBI GenBank.
Phylogenetic relationships among the nine Trichoderma isolates were investigated based on ITS and TEF1 sequences. The blasted DNA sequences were aligned using the Clustal W algorithm [38] with MEGAX software [39]. Multiple and pairwise alignment parameters were applied using a gap penalty of 15 and a gap length penalty of 6.66. Final alignment adjustments were made manually to remove artificial gaps. The analysis was conducted separately for the two partial gene sequences. The aligned sequences were then concatemerized and used for phylogenetic reconstruction. The evolutionary history was inferred by using the maximum likelihood method and the Tamura–Nei model [40]. The bootstrap consensus tree inferred from 1000 replicates was considered to represent the evolutionary history of the taxa analyzed. The initial tree(s) for the heuristic search were obtained automatically by applying Neighbor-Join and BioNJ algorithms to a matrix of pairwise distances estimated using the Tamura–Nei model and then selecting the topology with a superior log likelihood value. Evolutionary analyses were conducted using MEGA X.
2.5. Dual Confrontation Assays
The antagonistic activity of Trichoderma isolates against Pleurotus spp., phytopathogens (Botrytis cinerea, Fusarium oxysporum, Rhizoctonia solani, and Sclerotinia sclerotiorum), and Trichoderma-Trichoderma combinations were evaluated using a dual culture assay in vitro. Two mycelial plugs (5 mm diameter), obtained from each 7-day-old fungal culture, were placed at 0.25 mm from the border, on opposite sides of a Petri plate (9 cm diameter) containing PDA, then incubated at 25 °C. Plate cultures with the single isolate of each Trichoderma spp., were performed to themselves and to the different pathogens, or Pleurotus spp. Evaluation of the radial growth was recorded 7 days post-inoculation.
The growth inhibition percentage was calculated using the following formula:
where R = isolate radial growth in the control and DC = radial growth of the same isolate in the dual culture.
2.6. Effect of Fungicides on Fungal Growth
Prochloraz (Mirage® 45 EC, 450 g L−1; Adama Makhteshim Ltd., Beer Sheva, Israel) and metrafenone (Vivando® SC, 500 g L−1; BASF SE, Ludwigshafen am Rhein, Germany) effectively control many ascomycetes and deuteromycetes [41], such as Trichoderma, with minimal effects on basidiomycetes, such as Agaricus or Pleurotus.
A 5 mm disk of a young PDA culture of Trichoderma or Pleurotus was transferred to a 24-well plate containing 1 mL of PDB with different concentrations of fungicide (control containing untreated PDB) and then incubated at 25 °C in the dark. In particular, prochloraz was applied at 1, 0.7, 0.5, and 0.2 mL L−1, whereas metrafenone was applied at 10, 7, 5, and 2.5 μL L−1.
The colony growth was evaluated daily for the first 7 days using the established measurement scale based on five values: 0 = no apparent growth, 1 = 1–25%, 2 = 26–50%, 3 = 51–75%, and 4 = 76–100% good fungal growth and colony development compared to the untreated control (PDB).
The same experiment was performed by using a spore suspension of each Trichoderma isolate (1 × 105 sp mL−1) to determine the effect on the germination of conidia. The assay was terminated 30 days after spore inoculation. Each experiment included three replicates per treatment and was repeated twice.
2.7. Statistical Analyses
One-way ANOVA was performed using GraphPad Prism Software to test the effects of temperature and fungicide applications on Trichoderma strains, as well as on data from the dual culture assay Trichoderma-phytopathogens. The analysis of variance was corrected for multiple comparisons by LSD post hoc test considering a p-value ≤ 0.05 for the temperature assay and Tukey test (p-value ≤ 0.05) for all the other assays.
3. Results
3.1. Determination of Microbial Concentration
The number of colony-forming units (CFUs) obtained from the different P. ostreatus and P. eryngii production phases was variable, and the highest microbial counts were detected during the fermentation and fruitification phases (Table 1). Bacteria were detected in all stages of preparation, even after pasteurization, and were always present in concentrations greater than the fungi, ranging from 2.4 × 108 CFUs per gram of compost (CFU g−1) after pasteurization to 9.5 × 1011 CFU g−1 during fermentation. In comparison, Trichoderma spp. were found initially in the compost preparation, and at later stages during the incubation and fruiting stages of the Pleurotus in concentrations ranging from 7.1 × 102 to 5.8 × 108 CFU g−1, respectively. No fungi were obtained after pasteurization or during the phase immediately after seeding. Trichoderma spp. was always identified in the general fungi counts associated with the different processing stages. Further, both bacterial and fungal microbes were detected in the source of recycled water that was used throughout the compost preparation for wetting the substrate material.

Table 1.
Microbial concentrations found in compost sampled at different phases of P. ostreatus and P. eryngii production, the number of colony-forming units (CFU g−1) of bacteria and fungi, and specifically the presence of Trichoderma spp.
3.2. Fungal Growth and Morphological Characterization
A morphological analysis was conducted on the Trichoderma spp. isolated from infected compost (NZ-1 and NZ-2), 20 days after spawn seeding (GP-6-1, GP-6-2, GP-BI-4, GP-BI-6, GP-BI-8), in the phase of P. ostreatus fruitification (NZ-3), and in recycled water (GP-2-2).
The nine Trichoderma isolates were grown at different temperatures (25, 28, and 35 °C), and optimal mycelial growth and sporulation were observed at 25 °C two days after incubation (Figure 1A). No significant differences were noted in colony growth among the isolates of different Trichoderma species at 25 °C with the exception of NZ-2, which was the only isolate that grew better at 28 °C than at 25 °C (Figure 1A,B). In particular, a reduction of 35, 34, 31, and 14% was recorded for NZ-1, T22, A6, and GP-6-2, respectively, comparing the colony diameters at 25 and 28 °C (Figure 1A).

Figure 1.
Mycelial growth, determined by measuring the colony diameter (mm) of fungal isolates at 25 °C (grey bars) and 28 °C (black bars) of (A) Trichoderma at two days and (B) Pleurotus at three days after inoculation on PDA. Bars with different letters are significantly different (p-value ≤ 0.05) according to one-way ANOVA followed by the LSD post hoc test.
In general, the isolates of Pleurotus ostreatus and Pholiota aergerita (AFO) preferred a temperature of 28 °C for growth after three days, whereas Pleurotus eryngii (P47) grew better at 25 °C (Figure 1B). All Trichoderma isolates grew faster than all the tested species of Pleurotus at both growing temperatures assessed.
All Trichoderma isolates were able to grow over a wide range of pH values, but the optimal growth for most isolates occurred on substrates with a pH value of around 6 to 7 (Figure 2A). In contrast, the Pleurotus species grew better on alkaline substrates with the optimum for mycelium development at pH 8 to 9 (Figure 2B).

Figure 2.
Evaluation of fungal mycelium growth in Potato Dextrose Broth adjusted to different pH values as determined by measurement on a five-value scale, where 0 = no apparent fungal growth, 1 = growth 1–25% of the control (water), 2 = growth 26–50% of the control, 3 = growth 51–75% of the control, and 4 = growth 76–100% of the control of different isolates of (A) Trichoderma at two days and (B) Pleurotus at three days after inoculation.
3.3. Genetic and Morphological Characterization of Trichoderma Isolates
Partial sequences of translation elongation factor 1α (TEF1 ~ 600 bp), ribosomal polymerase β subunit (RPB ~ 800 bp), and internal transcribed spacers (ITS ~ 600 bp) genes were submitted to NCBI GenBank under accession numbers as reported in Table 2. Sequences were analyzed separately and compared to the NCBI non-redundant nucleotide database. TEF1 and ITS concatemeric sequences were found to be informative for the identification of new isolates. The multilocus phylogenetic analysis revealed that GP-6-1, GP-6-2, GP-BI-4, GP-BI-6, GP-BI-8, NZ-1, NZ-2, and NZ-3 isolates belonged to Trichoderma pleuroticola while strain GP-2-2 was identified as T. harzianum. Phylogenetic analysis was conducted with T. atroviride P1 and A6, T. afroharzianum T22, T. harzianum T1, and T. pleuroticola T1295 as references, and T. reesei AIT TRMS44c2 as the outgroup (Figure 3).

Table 2.
Isolates of Trichoderma used in this study and their origins. NAP—isolates conserved in the collection at the University of Naples, Portici (NA), Italy. This study *: isolates obtained in the present study and described in Komoń-Zelazowska et al. [30].

Figure 3.
Evolutionary analysis of ITS and TEF sequences performed using the maximum likelihood method. The evolutionary history was inferred by using the maximum likelihood method and the Tamura–Nei model [40]. The bootstrap consensus tree inferred from 1000 replicates [42] was used to represent the evolutionary history of the taxa analyzed. Branches corresponding to partitions reproduced in less than 50% of bootstrap replicates were collapsed. The percentage of replicate trees in which the associated taxa clustered together in the bootstrap test (1000 replicates) is shown next to the branches [42]. Initial tree(s) for the heuristic search were obtained automatically by applying Neighbor-Join and BioNJ algorithms to a matrix of pairwise distances estimated using the Tamura–Nei model and then selecting the topology with a superior log likelihood value. This analysis involved 15 nucleotide sequences. Evolutionary analyses were conducted using MEGA X [39].
The morphological and physiological characteristics of Trichoderma spp. were evaluated by growing cultures on PDA for 96 h at 35 °C. T. atroviride isolates did not grow, and no spores or pigmentation was observed. In contrast, T. afroharzianum T22 grew rapidly, more extensively (50 to 86 mm), and sporulated well; T. harzianum GP-2-2 grew slower, forming clear concentric rings of white, cottony aerial mycelium alternating with zones of green spores (Figure 4).

Figure 4.
Morphological and physiological characteristics of Trichoderma isolates grown for 96 h at 35 °C on PDA described as colony diameter (mm): fungal growth; species: Trichoderma species identifications determined by NCBI blast analysis; mycelial development: phenology of fungal colony; colony margin: form of colony; green spores and yellow pigmentation: sporulation and presence of green conidia and/or yellow pigmentation.
On the contrary, T. pleuroticola growth was particular and distinct from the other species. The colony diameters ranged from 30 to 53 mm, with irregular growth, exhibiting a dense circular white-cream mycelium at the centre, bordered externally with a dark yellow to yellow-brown zone. Moreover, multiple sectors of finely diffuse mycelium extending outwards and culminating with variable, lobed, wavy margins were observed. Sporulation was non-existent or very sparse in the central region of the colony (Figure 4).
All isolates of Trichoderma sporulated by the end of the experiment and produced conidia that were globose to subglobose (length-to-width ratio 1.1 to 1.2), smooth, and green in colour (light yellow-green to dark green-blue). All Trichoderma were able to grow over the Pleurotus fungal colonies, exhibiting “normal” mycelium and spore development, similarly to the biocontrol reference isolates. A fungal antagonistic effect was clearly observed when confrontations were conducted between the Trichoderma isolates (in particular NZ-2), including the biological control strains (i.e., P1), and various fungal plant pathogens, such as Botrytis cinerea, Rhizoctonia solani, Sclerotinia sclerotiorum, or Fusarium oxysporum (Table 3). As shown in Figure 5, in some Trichoderma-Trichoderma combinations, particularly those involving the biocontrol isolates, a clear inhibition zone and/or competition for space and nutrients were observed in confrontations: GP-6-1 vs. P1, A6 vs. NZ-3, NZ-1 vs. T22, and P1 vs. T22, indicating that an antagonistic response can be produced among members of the same fungal genus (interspecies).

Table 3.
Dual culture assay of best-performing Trichoderma isolates against different phytopathogens (Botrytis cinerea, Fusarium oxysporum, Rhizoctonia solani, and Sclerotinia sclerotiorum) evaluating the percentage of radial growth inhibition. Statistical data analysis was performed using one-way ordinary ANOVA followed by Tukey’s multiple comparisons test considering a p-value ≤ 0.05; ns: not significant; *: p-value ≤ 0.05; **: p-value ≤ 0.01; ***: p-value ≤ 0.001; ****: p-value ≤ 0.0001; CI: confidence interval for a difference between means.
Figure 5.
Dual culture assay of Trichoderma-Trichoderma interaction. (A) T. pleuroticola GP-6-1 (bottom) vs. T. atroviride P1 (top); (B) T. atroviride A6 (bottom) vs. T. pleuroticola NZ-3 (top); (C) T. pleuroticola NZ-1 (bottom) vs. T. afroharzianum T22 (top); (D) T. atroviride P1 (bottom) vs. T. afroharzianum T22 (top).
3.4. Treatment with Chemical Fungicides
Chemical fungicides containing prochloraz (Mirage® 45 EC, 450 g L−1; Adama Makhteshim Ltd., Beer Sheva, Israel) and metrafenone (Vivando® SC, 500 g L−1; BASF SE, Ludwigshafen am Rhein, Germany), applied at different doses, were effective in inhibiting both the mycelium development and spore germination of the inoculated Trichoderma species after three days (Figure 6A,B).

Figure 6.
Effect of different fungicides, applied at various concentrations (a.i.  = highest dose,
= highest dose,  = second dose,
= second dose,  = third dose,
= third dose,  = lowest dose tested) of the active ingredient in 1 L of water, on the mycelial growth of Trichoderma isolates three days after treatment with (A) prochloraz (1, 0.7, 0.5, 0.2 mL) and (B) metrafenone (10, 7, 5, 2.5 μL). Fungal growth was measured on a five-value scale, where 0 = no apparent growth of the inoculum, 1 = 1–25%, 2 = 26–50%, 3 = 51–75%, and 4 = 76–100% fungal colony development with respect to the control (PDB).
= lowest dose tested) of the active ingredient in 1 L of water, on the mycelial growth of Trichoderma isolates three days after treatment with (A) prochloraz (1, 0.7, 0.5, 0.2 mL) and (B) metrafenone (10, 7, 5, 2.5 μL). Fungal growth was measured on a five-value scale, where 0 = no apparent growth of the inoculum, 1 = 1–25%, 2 = 26–50%, 3 = 51–75%, and 4 = 76–100% fungal colony development with respect to the control (PDB).
 = highest dose,
= highest dose,  = second dose,
= second dose,  = third dose,
= third dose,  = lowest dose tested) of the active ingredient in 1 L of water, on the mycelial growth of Trichoderma isolates three days after treatment with (A) prochloraz (1, 0.7, 0.5, 0.2 mL) and (B) metrafenone (10, 7, 5, 2.5 μL). Fungal growth was measured on a five-value scale, where 0 = no apparent growth of the inoculum, 1 = 1–25%, 2 = 26–50%, 3 = 51–75%, and 4 = 76–100% fungal colony development with respect to the control (PDB).
= lowest dose tested) of the active ingredient in 1 L of water, on the mycelial growth of Trichoderma isolates three days after treatment with (A) prochloraz (1, 0.7, 0.5, 0.2 mL) and (B) metrafenone (10, 7, 5, 2.5 μL). Fungal growth was measured on a five-value scale, where 0 = no apparent growth of the inoculum, 1 = 1–25%, 2 = 26–50%, 3 = 51–75%, and 4 = 76–100% fungal colony development with respect to the control (PDB).
T. atroviride (P1 and A6) and some T. pleuroticola isolates were more susceptible to prochloraz, remaining at 25% growth compared to the control, whereas NZ-2, NZ-3, GP-2-2, and T22 reached 50% growth, suggesting a lower efficacy of the active ingredient at the tested doses (Figure 6A). Generally, the control effects on the fungal mycelium growth observed 3 days after fungicide treatments were maintained for up to 30 days following the initial application.
In addition, when the same dose of prochloraz was applied to a Trichoderma spore suspension (105 sp mL−1), an inhibitory effect on spore germination and spore tube elongation was observed at a similar level to that recorded for the mycelium growth inhibition (1–50%), even up to 30 days after treatment (data not shown).
The applications of metrafenone were effective in controlling the growth of the Trichoderma isolates (25%) at higher dose concentrations. An exception was NZ-2, which demonstrated 50% growth at the highest doses of fungicide; however, since there was minimal growth at lower doses, this was probably an experimental artifact. T. atroviride A6 and P1 did not grow at any of the assayed fungicide doses of metrafenone, and T. harzianum GP-2-2 was inhibited at 10 and 7 μL concentrations (Figure 6B). On the other hand, treatments with the same active ingredient directly applied to conidium suspensions completely inhibited spore germination (0%) of all Trichoderma isolates, an effect that was maintained after 30 days.
None or minimal negative effects were observed on mycelium growth of commercial Pleurotus varieties treated with prochloraz or metrafenone applied at the same doses. In particular, P. ostreatus PC3 resulted in the only isolate significantly inhibited by the highest doses of both fungicides (Table 4).

Table 4.
Effect of chemical fungicides (prochloraz and metrafenone) applied at different doses on P. ostreatus PC3 isolate. Statistical data analysis was performed using one-way ordinary ANOVA followed by Tukey’s multiple comparisons test considering a p-value ≤ 0.05; ns: not significant; *: p-value ≤ 0.05; **: p-value ≤ 0.01.
4. Discussion
The Trichoderma species found to be associated with the production of Pleurotus mushrooms in Italy were identified as T. harzianum and T. pleuroticola. These species could be readily cultured on a common fungal medium such as PDA and grew after incubation at 25°–28° C for 96 h. When assessed at 35 °C, the reference isolates T. atroviride P1 and A6 grew minimally or did not grow, T22 appeared normal, whereas irregular mycelial growth was noted for eight isolates of T. pleuroticola and the single T. harzianum (GP2-2) obtained from Pleurotus. Further, the T. pleuroticola species could be readily distinguished from the others because they grew slower and produced a yellow/yellow-brown pigmentation in the substrate.
In this study, the production process of oyster mushrooms involved cultivation in a pasteurized straw-based compost, inoculation with seed spawn, and packaging into bales covered with perforated plastic. The bales were subsequently piled together and placed under controlled conditions of pre-incubation at 25 °C to permit growth and diffusion of the Pleurotus mycelium in the compost, thus reducing the time to fruiting body formation after distribution to mushroom producers. Microbial analysis conducted during all phases of compost preparation indicated that Trichoderma spp. was eliminated by pasteurization at 60 °C (Table 1). T. pleuroticola was isolated from phases after pasteurization (from infected compost), 20 days after spawn seeding, and at the stage of fruiting body formation. This suggested that the heat-treated compost needed to be separated and isolated from the other zones of production to avoid the cross-contamination of fungal spores (air movement, dust, etc.) from the infected material after pasteurization. In addition, the spawn should be seeded as soon as possible to freshly pasteurized compost in a closed or air-filtered clean environment, and then baled immediately afterwards to maintain its integrity. Furthermore, T. harzianum was isolated from the recycled water used in the process. Importantly, any material found infested with Trichoderma spp. during the production phases should be removed and eliminated to prevent distribution and infection.
At 25 °C, no differences were observed between the colony growth of T. pleuroticola, T. harzianum, T. afroharzianum, and T. atroviride. The initial occurrence of any Trichoderma in the mushroom compost at spawning and subsequently during incubation at 25 °C, provides a colonization advantage for the pathogen over the cultivated Pleurotus, which grows preferentially at 28 °C and develops much slower. This is in contrast to the findings of Rakhmonov et al., [43], who detected an optimum temperature for Pleurotus growth in the substrate at 26 °C. Only growth at 35 °C differentiated the morphological characteristics of the Trichoderma species in plate cultures (Figure 4). Although T. pleuroticola growth was somewhat inhibited at higher temperatures, the development of other species such as T. harzianum was not; therefore, temperature cannot be considered a good physical method to control Trichoderma infestations.
All the tested Trichoderma species grew similarly and preferentially at a neutral pH (pH 6 to 7). In general, the crude straw-based substrate has a pH of about 7.5 and is mixed with alkaline compounds such as volcanic tuff rock (locally found around Naples) and/or calcium carbonate powders to increase the alkalinity to pH 8.5 or higher. However, the subsequent processing and growth of the oyster mushrooms rapidly decrease the pH of the compost such that a developing Pleurotus bale is reduced to pH 6.7 after one week and to pH 6.2 after two weeks of incubation. Considering that alkaline pH inhibits Trichoderma spp. development, it is important to establish a substrate that maintains alkalinity, particularly in the beginning phases of production, to maintain the conditions preferential for Pleurotus growth and development.
A literature search was conducted to identify fungicides other than prochloraz and metrafenone suggested for controlling Trichoderma spp. in Agaricus. These included benzimidazole, thiabendazole or thiophanate-methyl, and azole fungicides, which are inhibitors of ergosterol synthesis such as propiconazole [44,45,46]. In addition, a mix of thiabendazole, thiofanate-methyl, and dicloran was reported to be effective for the control of Trichoderma isolates that attack champignons, whereas carbendazim was found to be very successful [44,46,47]. Prochloraz (application dose 1 L ha−1) and metrafenone (10 L ha−1) are chemical fungicides used to control various fungal pathogens, with minimal effects on cultivated edible mushrooms. Both products were effective in controlling the development of established Trichoderma mycelium in vitro after three days; an inhibitory effect that was maintained or increased 30 days after treatment. Further, the same doses applied to the resistant fungal structures such as spores were able to inhibit both germination and hyphal growth. The application of metrafenone was more effective in controlling the growth of Trichoderma isolates at all tested concentrations. In particular, in agreement with Luković et al. and Allaga et al. [18,48], the commercial fungicide metrafenone showed an inhibitory effect on the growth of the examined Trichoderma strains, efficiently suppressing green mould isolates belonging to T. harzianum and T. pleuroticola species.
No detrimental effects of these compounds were observed on the majority of Pleurotus isolates at all tested concentrations, with the exception of PC3 isolate, which was significantly inhibited at the highest doses of both fungicides.
5. Conclusions
Our findings revealed that T. pleuroticola and T. harzianum associated with the production of Pleurotus emerged as opportunistic invaders that readily infected and colonized the compost substrate, thus resulting in competitors for oyster mushroom cultivation. All isolated Trichoderma species were genetically identified using molecular sequencing approaches and assigned to Trichoderma pleuroticola and T. harzianum species. The results highlighted that it is possible to manipulate physical parameters, including temperature and pH, that control Trichoderma spp. infections, but can favour Pleurotus growth. In addition, chemical treatments with metrafenone were effective in containing Trichoderma growth in vitro, suggesting that its application directly to the Pleurotus spawn or to the compost at the beginning can provide efficient control of potential Trichoderma infections, thereby permitting the oyster mushrooms to establish on the substrate. In general, good sanitation practices in Pleurotus cultivation are required to avoid Trichoderma infection, dissemination, and contamination, and to reduce risks of outside infestations by the immediate removal and destruction of any infected material, and the isolation of the compost-producing/seeding zone from the growing/incubation and transport zones. If possible, the production should be conducted in an enclosed zone, with the filtration of circulating air in the ventilation system and the filtration of recycled water used in the process. Other methods to reduce potential Trichoderma attacks include the preparation of compost with an alkaline pH 8-9, an initial fungicide treatment of the Pleurotus spawn with prochloraz and/or metrafenone at seeding, followed by incubation at higher temperatures of 28 °C in order to aid the development and establishment of oyster mushroom cultures.
Author Contributions
Conceptualization, S.L.W. and M.L.; methodology, N.L., A.P., and G.M., validation, S.L.W., N.L., and G.M.; formal analysis, F.V., and S.V.; data curation, A.P., and R.M.; writing—original draft preparation, N.L., and S.L.W.; writing—review and editing, N.L., S.L.W., and G.M. All authors have read and agreed to the published version of the manuscript.
Funding
This research was supported by funding from PRIN 2008—L’induzione di resistenza come strategia di lotta a patogeni fungini delle mele in post-raccolta (No. 2008SNPNC2); CARINA, Regione Campania POR-FSE, D.D. BURC n. 33 del 30/05/11; and PURE: “Pesticide Use-and-risk Reduction in European farming systems with Integrated Pest Management” (n° 265865 in FP7 KBBE.2010.1.2-05) “Integrated pest management in farming systems of major importance for Europe”.
Institutional Review Board Statement
Not applicable.
Informed Consent Statement
Not applicable.
Data Availability Statement
The datasets used and/or analyzed during the current study are available from the corresponding authors upon reasonable request.
Acknowledgments
The authors thank Gerardo Puopolo, Ferdinando Zaccaria, and Alessandro De Vivo for their assistance in collecting samples, and Mario De Martino for supporting the study. Further, the contributions by Christian P. Kubicek and Irina S. Druzhinina to the sequencing and taxonomic identifications are acknowledged.
Conflicts of Interest
The authors declare no conflict of interest.
References
- Klein, D.; Eveleigh, D.E. Ecology of Trichoderma. Trichoderma and Gliocladium; Kubicek, C.P., Harman, G.E., Eds.; Taylor & Francis Ltd.: London, UK, 1998; Volume 1, pp. 57–74. [Google Scholar]
- Harman, G.E. Overview of Mechanisms and Uses of Trichoderma spp. Phytopathology 2006, 96, 190–194. [Google Scholar] [CrossRef] [PubMed]
- Lorito, M.; Woo, S.L. Trichoderma: A Multi-Purpose Tool for Integrated Pest Management. In Principles of Plant-Microbe Interactions; Springer International Publishing: Cham, Switzerland, 2015; pp. 345–353. [Google Scholar]
- Ghazanfar, M.U.; Raza, M.; Raza, W.; Qamar, M.I. Trichoderma as Potential Biocontrol Agent, Its Exploitation in Agriculture: A Review. Plant Prot. 2018, 2, 109–135. [Google Scholar]
- Woo, S.L.; Ruocco, M.; Vinale, F.; Nigro, M.; Marra, R.; Lombardi, N.; Pascale, A.; Lanzuise, S.; Manganiello, G.; Lorito, M. Trichoderma-Based Products and Their Widespread Use in Agriculture. Open Mycol. J. 2014, 8, 71–126. [Google Scholar] [CrossRef]
- Zin, N.A.; Badaluddin, N.A. Biological Functions of Trichoderma spp. for Agriculture Applications. Ann. Agric. Sci. 2020, 65, 168–178. [Google Scholar] [CrossRef]
- Sood, M.; Kapoor, D.; Kumar, V.; Sheteiwy, M.S.; Ramakrishnan, M.; Landi, M.; Araniti, F.; Sharma, A. Trichoderma: The “Secrets” of a Multitalented Biocontrol Agent. Plants 2020, 9, 762. [Google Scholar] [CrossRef]
- Seaby, D.A. Differentiation of Trichoderma Taxa Associated with Mushroom Production. Plant Pathol. 1996, 45, 905–912. [Google Scholar] [CrossRef]
- Ospina-Giraldo, M.D.; Royse, D.J.; Chen, X.; Romaine, C.P. Molecular Phylogenetic Analyses of Biological Control Strains of Trichoderma harzianum and Other Biotypes of Trichoderma spp. Associated with Mushroom Green Mold. Phytopathology 1999, 89, 308–313. [Google Scholar] [CrossRef]
- Royse, D.J.; Boomer, K.; Du, Y.; Handcock, M.; Coles, P.S.; Romaine, C.P. Spatial Distribution of Green Mold Foci in 30 Commercial Mushroom Crops. Plant Dis. 1999, 83, 71–76. [Google Scholar] [CrossRef]
- Mamoun, M.L.; Savoie, J.-M.; Olivier, J.-M. Interactions between the Pathogen Trichoderma harzianum Th2 and Agaricus bisporus in Mushroom Compost. Mycologia 2000, 92, 233–240. [Google Scholar] [CrossRef]
- Sharma, H.S.S.; Kilpatrick, M.; Ward, F.; Lyons, G.; Burns, L. Colonisation of Phase II Compost by Biotypes of Trichoderma harzianum and Their Effect on Mushroom Yield and Quality. Appl. Microbiol. Biotechnol. 1999, 51, 572–578. [Google Scholar] [CrossRef]
- Samuels, G.J.; Dodd, S.L.; Gams, W.; Castlebury, L.A.; Petrini, O. Trichoderma Species Associated with the Green Mold Epidemic of Commercially Grown Agaricus bisporus. Mycologia 2002, 94, 146–170. [Google Scholar] [CrossRef] [PubMed]
- Seaby, D.; Harman, G.E. Trichoderma and Gliocladium; Harman, G.E., Kubicek, C.P., Eds.; CRC Press: Boca Raton, FL, USA, 1998; Volume 2, ISBN ISBN 9780429079641. [Google Scholar]
- Rinker, D.L.; Alm, G. Investigations of Factors Influencing the Expression of Green Mould. Mushroom World 1997, 8, 25–29. [Google Scholar]
- Seaby, D.A. Infection of Mushroom Compost by Trichoderma Species. Mushroom J. 1987, 179, 355–361. [Google Scholar]
- Woo, S.L.; Di Benedetto, P.; Senatore, M.; Abadi, K.; Gigante, S.; Soriente, I.; Ferraioli, S.; Lorito, M. Identification and Characterization of Trichoderma Species Aggressive to Pleurotus in Italy. J. Zhejiang Univ. Agric. Life Sci. 2004, 30, 469–470. [Google Scholar]
- Allaga, H.; Zhumakayev, A.; Büchner, R.; Kocsubé, S.; Szűcs, A.; Vágvölgyi, C.; Kredics, L.; Hatvani, L. Members of the Trichoderma harzianum Species Complex with Mushroom Pathogenic Potential. Agronomy 2021, 11, 2434. [Google Scholar] [CrossRef]
- Hermosa, M.R.; Grondona, I.; Iturriaga, E.A.; Diaz-Minguez, J.M.; Castro, C.; Monte, E.; Garcia-Acha, I. Molecular Characterization and Identification of Biocontrol Isolates of Trichoderma spp. Appl. Environ. Microbiol. 2000, 66, 1890–1898. [Google Scholar] [CrossRef]
- Largentau-Mamoun, M.L.; Mata, G.; Savoie, J.M. Green Mold Disease: Adaptation of Trichoderma harzianum Th2 to Mushroom Compost. In Mushroom Biology and Mushroom Products; Sanchez, E., Huerta, G., Mondel, E., Eds.; Universidad Autonoma Del Estado De Morelos: Cuernavaca, Mexico, 2002; Volume 4. [Google Scholar]
- Elbagory, M.; El-Nahrawy, S.; Omara, A.E.-D.; Eid, E.M.; Bachheti, A.; Kumar, P.; Abou Fayssal, S.; Adelodun, B.; Bachheti, R.K.; Kumar, P.; et al. Sustainable Bioconversion of Wetland Plant Biomass for Pleurotus ostreatus Var. Florida Cultivation: Studies on Proximate and Biochemical Characterization. Agriculture 2022, 12, 2095. [Google Scholar] [CrossRef]
- Werghemmi, W.; Abou Fayssal, S.; Mazouz, H.; Hajjaj, H.; Hajji, L. Olive and Green Tea Leaves Extract in Pleurotus ostreatus Var. Florida Culture Media: Effect on Mycelial Linear Growth Rate, Diameter and Growth Induction Index. IOP Conf. Ser. Earth Environ. Sci. 2022, 1090, 012020. [Google Scholar] [CrossRef]
- Kredics, L.; Naeimi, S.; Hatvani, L.; Vágvölgyi, C.; Cai, F.; Druzhinina, I.S.; Manczinger, L. ‘The Good, the Bad and the Ugly’ in the Shades of Green: The Genus Trichoderma in the Spotlight. Indian Phytopathol. 2021, 74, 403–411. [Google Scholar] [CrossRef]
- Sánchez-Montesinos, B.; Santos, M.; Moreno-Gavíra, A.; Marín-Rodulfo, T.; Gea, F.J.; Diánez, F. Biological Control of Fungal Diseases by Trichoderma aggressivum f. europaeum and Its Compatibility with Fungicides. J. Fungi 2021, 7, 598. [Google Scholar] [CrossRef]
- Muthumeenakshi, S.; Mills, P.R.; Brownd, A.E.; Seaby, D.A. Intraspecific Molecular Variation among Trichoderma harzianum Isolates Colonizing Mushroom Compost in the British Isles. Microbiology 1994, 140, 769–777. [Google Scholar] [CrossRef] [PubMed]
- Hermosa, M.R.; Grondona, I.; Monte, E. Isolation of Trichoderma harzianum Th2 from Commercial Mushroom Compost in Spain. Plant Dis. 1999, 83, 591. [Google Scholar] [CrossRef]
- Chen, X.; Romaine, C.P.; Ospina-Giraldo, M.D.; Royse, D.J. A Polymerase Chain Reaction-Based Test for the Identification of Trichoderma harzianum Biotypes 2 and 4, Responsible for the Worldwide Green Mold Epidemic in Cultivated Agaricus bisporus. Appl. Microbiol. Biotechnol. 1999, 52, 246–250. [Google Scholar] [CrossRef]
- Chen, X.; Romaine, C.P.; Tan, Q.; Schlagnhaufer, B.; Ospina-Giraldo, M.D.; Royse, D.J.; Huff, D.R. PCR-Based Genotyping of Epidemic and Preepidemic Trichoderma Isolates Associated with Green Mold of Agaricus bisporus. Appl. Environ. Microbiol. 1999, 65, 2674–2678. [Google Scholar] [CrossRef]
- Park, M.S.; Bae, K.S.; Yu, S.H. Two New Species of Trichoderma Associated with Green Mold of Oyster Mushroom Cultivation in Korea. Mycobiology 2006, 34, 111. [Google Scholar] [CrossRef]
- Komoń-Zelazowska, M.; Bissett, J.; Zafari, D.; Hatvani, L.; Manczinger, L.; Woo, S.; Lorito, M.; Kredics, L.; Kubicek, C.P.; Druzhinina, I.S. Genetically Closely Related but Phenotypically Divergent Trichoderma Species Cause Green Mold Disease in Oyster Mushroom Farms Worldwide. Appl. Environ. Microbiol. 2007, 73, 7415–7426. [Google Scholar] [CrossRef] [PubMed]
- Park, M.-S.; Seo, G.-S.; Lee, K.-H.; Bae, K.-S.; Yu, S.-H. Morphological and Cultural Characteristics of Trichoderma spp. Associated with Green Mold of Oyster Mushroom in Korea. Plant Pathol. J. 2005, 21, 221–228. [Google Scholar] [CrossRef]
- Park, M.S.; Seo, G.S.; Lee, K.H.; Bae, K.S.; Yu, S.H. Characterization of Trichoderma spp. Associated with Green Mold of Oyster Mushroom by PCR-RFLP and Sequence Analysis of ITS Regions of rDNA. Plant Pathol. J. 2005, 21, 229–236. [Google Scholar] [CrossRef]
- Nongthombam, J.; Kumar, A.; Ladli, B.; Madhushekhar, M.; Patidar, S. A Review on Study of Growth and Cultivation of Oyster Mushroom. Plant Cell Biotech. Mol. Biol. 2021, 22, 55–65. [Google Scholar]
- Bellettini, M.B.; Bellettini, S.; Fiorda, F.A.; Pedro, A.C.; Bach, F.; Fabela-Morón, M.F.; Hoffmann-Ribani, R. Diseases and Pests Noxious to Pleurotus spp. Mushroom Crops. Rev. Argent. Microbiol. 2018, 50, 216–226. [Google Scholar] [CrossRef] [PubMed]
- Kredics, L.; Kocsubé, S.; Nagy, L.; Komoń-Zelazowska, M.; Manczinger, L.; Sajben, E.; Nagy, A.; Vágvölgyi, C.; Kubicek, C.P.; Druzhinina, I.S.; et al. Molecular Identification of Trichoderma Species Associated with Pleurotus ostreatus and Natural Substrates of the Oyster Mushroom. FEMS Microbiol. Lett. 2009, 300, 58–67. [Google Scholar] [CrossRef] [PubMed]
- Gams, W.; Bissett, J. Morphology and Identification of Trichoderma. In Trichoderma and Gliocladium; Volume 1: Basic Biology, Taxonomy and Genetics; Kubicek, C.P., Harman, G.E., Eds.; Taylor & Francis Ltd.: London, UK, 1998; pp. 3–34. [Google Scholar]
- Manganiello, G.; Nicastro, N.; Caputo, M.; Zaccardelli, M.; Cardi, T.; Pane, C. Functional Hyperspectral Imaging by High-Related Vegetation Indices to Track the Wide-Spectrum Trichoderma Biocontrol Activity Against Soil-Borne Diseases of Baby-Leaf Vegetables. Front. Plant. Sci. 2021, 12, 630059. [Google Scholar] [CrossRef] [PubMed]
- Thompson, J.D.; Higgins, D.G.; Gibson, T.J. CLUSTAL W: Improving the Sensitivity of Progressive Multiple Sequence Alignment through Sequence Weighting, Position-Specific Gap Penalties and Weight Matrix Choice. Nucleic Acids Res. 1994, 22, 4673–4680. [Google Scholar] [CrossRef] [PubMed]
- Kumar, S.; Stecher, G.; Li, M.; Knyaz, C.; Tamura, K. MEGA X: Molecular Evolutionary Genetics Analysis across Computing Platforms. Mol. Biol. Evol. 2018, 35, 1547–1549. [Google Scholar] [CrossRef]
- Tamura, K.; Nei, M. Estimation of the Number of Nucleotide Substitutions in the Control Region of Mitochondrial DNA in Humans and Chimpanzees. Mol. Biol. Evol. 1993, 10, 512–526. [Google Scholar] [CrossRef]
- Zhao, H.; Yang, G.; Liu, Y.; Ye, H.; Qi, X.; Wang, Q. Residual Behavior and Risk Assessment of Prochloraz in Bayberries and Bayberry Wine for the Chinese Population. Environ. Monit. Assess. 2019, 191, 644. [Google Scholar] [CrossRef]
- Felsenstein, J. Confidence Limits on Phylogenies: An Approach Using the Bootstrap. Evolution 1985, 39, 783–791. [Google Scholar] [CrossRef]
- Rakhmonov, U.; Soatov, T. Harmful Competitors and Diseases of Pleurotus ostreatus and Their Control Measures. E3S Web Conf. 2023, 389, 03101. [Google Scholar] [CrossRef]
- Rinker, D.L.; Alm, G. Effectiveness of Benomyl-Coated Spawn against Green Mould Disease. Mushroom World 1998, 9, 15–20. [Google Scholar]
- Chang, S.T.; Miles, P.G. Mushrooms Cultivation, Nutritional Value, Medicinal Effect, and Environmental Effect; CRC Press LLC: Boca Raton, FL, USA, 2004. [Google Scholar]
- Gaze, R.H.; Fletcher, J.T. Mushroom Pest and Disease Control: A Color Handbook; Academic Press: Burlington, MA, USA, 2008. [Google Scholar]
- Grogan, H.M.; Gaze, R.H. Growth of Trichoderma Harzianum in Traditional and Experimental Composts; Elliott, T.J., Ed.; Balkema: Rotterdam, The Netherlands, 1995. [Google Scholar]
- Luković, J.; Milijašević-Marčić, S.; Hatvani, L.; Kredics, L.; Szűcs, A.; Vágvölgyi, C.; Duduk, N.; Vico, I.; Potočnik, I. Sensitivity of Trichoderma Strains from Edible Mushrooms to the Fungicides Prochloraz and Metrafenone. J. Environ. Sci. Health Part B 2021, 56, 54–63. [Google Scholar] [CrossRef] [PubMed]
Disclaimer/Publisher’s Note: The statements, opinions and data contained in all publications are solely those of the individual author(s) and contributor(s) and not of MDPI and/or the editor(s). MDPI and/or the editor(s) disclaim responsibility for any injury to people or property resulting from any ideas, methods, instructions or products referred to in the content. |
© 2023 by the authors. Licensee MDPI, Basel, Switzerland. This article is an open access article distributed under the terms and conditions of the Creative Commons Attribution (CC BY) license (https://creativecommons.org/licenses/by/4.0/).






